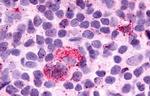
GPR25 Antibody in Immunohistochemistry (Paraffin) (IHC (P))

Search
Invitrogen
GPR25 Polyclonal Antibody
{{$productOrderCtrl.translations['antibody.pdp.commerceCard.promotion.promotions']}}
{{$productOrderCtrl.translations['antibody.pdp.commerceCard.promotion.viewpromo']}}
{{$productOrderCtrl.translations['antibody.pdp.commerceCard.promotion.promocode']}}: {{promo.promoCode}} {{promo.promoTitle}} {{promo.promoDescription}}. {{$productOrderCtrl.translations['antibody.pdp.commerceCard.promotion.learnmore']}}
产品信息
PA5-33681
种属反应
宿主/亚型
分类
类型
抗原
偶联物
形式
浓度
规格
纯化类型
保存液
内含物
保存条件
运输条件
RRID
产品详细信息
Percent identity with other species by BLAST analysis: Human, Gorilla, Monkey (100%) Mouse, Rat, Hamster (84%).
靶标信息
The G-protein-coupled receptor (GPCR) superfamily is comprised of an estimated 600-1,000 members and is the largest known class of molecular targets with proven therapeutic value. GPR25 is an intronless, orphan GPCR with highest homology to GPR15, angiotensin II type 1A receptor, and somatostatin receptor 5. GPR25 has been linked to arterial stiffness. Human GPR25 is cleaved at amino acid residues 315-316 by HIV-1 protease.
仅用于科研。不用于诊断过程。未经明确授权不得转售。
篇参考文献 (0)
生物信息学
蛋白别名: C-X-C chemokine receptor GPR25; G-protein coupled receptor 25
基因别名: GPR25
UniProt ID: (Human) O00155
Entrez Gene ID: (Human) 2848